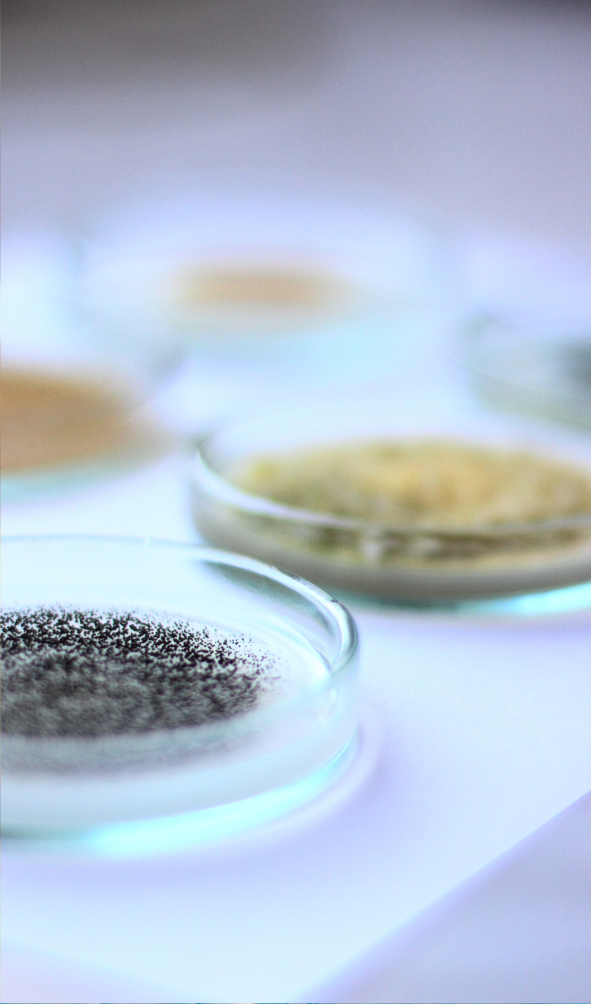
petri dish

Absent global efforts to mitigate antimicrobial resistance (AMR) with better surveillance and concerted action, we face a post-antibiotic era. OHT/CDDEP researchers are leading data collection and analysis in Africa for the Mapping Antimicrobial Resistance and Antimicrobial Use Partnership (MAAP) consortium to determine the extent of the continent’s AMR crisis.

The MAAP project has collected retrospective data on antimicrobial resistance and use from public and private laboratories and pharmacies throughout Africa, taking advantage of established networks among consortium partners and in-country systems. Antimicrobial susceptibility test results for different bug-drug combinations and specimens (both bacterial and fungal) were used to estimate levels of antimicrobial resistance and its links with clinical variables.
The key activities conducted by OHT during the course of the study, were as follows:
- The OHT team developed and executed the methodologies on laboratory selection, data analysis,, and estimation of AMR rates and drivers.
- These methodologies were shared with all partners and country representatives for their review and feedback, during the country workshops.
- In addition, there was a weekly exchange of information with all the strategic and technical partners through regular calls.
- OHT was responsible for drafting and finalizing the AMR reports for all 14 countries and also disseminated findings at various fora organized by ASLM.

The key findings of this study are:
- Bacteriology testing is done in only 1.3 percent of the biology laboratories across the 14 participating countries.
- Out of the 205 participating laboratories, only 26 percent of the labs use electronic laboratory information systems.
- 80 percent of the labs conduct less than 1,000 antimicrobial susceptibility tests every year.
- 12 African countries have DRIs (Drug Resistance Indexes) that indicate that AMR is a major health hazard.
- In 8 of the 14 countries, over half of the population don’t have access to any bacteriology laboratory.
- Out of all the samples (187,000) tested for AMR, nearly 88 percent had no data on the clinical profiles of patients, including the origin/diagnosis of infection and antimicrobial usage.
- There is limited access to some groups of antibiotics, especially the stronger drugs required for treating resistant infections.
Factors that Drive AMR (at patient and country levels)
Certain patient populations were found to be at a greater risk of acquiring antimicrobial resistant infections (though further studies are required to confirm the same). For example, patients on prior antibiotics had a higher rate of antimicrobial resistance than the counterfactual group.

Our partners from MAAP consortium include:
- African Society for Laboratory Medicine (ASLM)
- Africa Centers for Disease Control and Prevention
- West African Health Organization (WAHO)
- East Central & Southern Africa Health Community (ECSA-HC)
- IQVIA
- Innovative Support to Emergencies, Diseases and Disasters (InSTEDD)
Funded by the Fleming Fund Regional Grant







